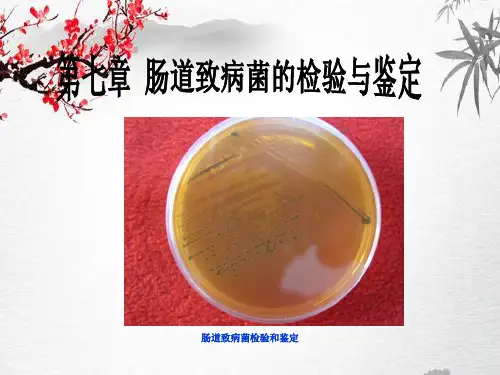

肠道致病菌(本科)
- 格式:doc
- 大小:51.00 KB
- 文档页数:11

医学微生物学练习题一名词解释微生物病原微生物消毒灭菌无菌无菌操作正常菌群菌群失调症菌血症毒血症败血症脓毒血症病毒干扰素院内感染人工自动免疫垂直传播二选择题(单选)1 下述有关微生物的描述正确的是:EA 体形小于1mm的生物B 单细胞生物C 不具备细胞结构的微生物D 体形小于1um的生物E 以上均是错误的2 属于非细胞型微生物的是:DA 衣原体B 支原体C 放线菌D 病毒E 真菌3 细菌属于原核细胞型微生物的主要依据是EA 单细胞,结构简单B 二分裂方式繁殖C 有细胞壁D 对抗生素敏感E 原始核,细胞器不完善4 下列不属于原核细胞型微生物的是:EA 细菌B 衣原体C 支原体D 放线菌E 病毒5 细菌细胞壁的主要成分是:EA 磷壁酸B 外膜C 脂多糖D 蛋白质E 粘肽6 细菌细胞膜的功能不包括:EA 物质交换B 呼吸作用C 合成和分泌作用D 物质转运E 维持细菌的外形7 G+菌细胞壁的特点是:CA 较疏松B 无磷壁酸C 肽聚糖含量多D 有脂多糖E 有脂蛋白8 具有抗吞噬作用的细菌特殊结构为:CA 芽孢B细胞壁 C 荚膜 D 鞭毛E 细胞膜9 青霉素类抗生素杀菌机理为:EA 破坏磷壁酸B 损伤细胞膜C 干扰核糖体上菌体蛋白质的合成D 破坏肽聚糖骨架E 抑制四肽侧链与甘氨酸交联桥之间连接10 细菌缺乏下列哪种结构时,在一定条件下仍可存活?AA 细胞壁B 细胞膜C 细胞质D 核质E 以上均可11 有关质粒的描述,下列哪项错误?DA 为染色体外的遗传物质B 具有自我复制的特点C 可自行丢失D 细菌生命活动不可少的基因E 可从一个菌转移给另一菌12 细菌的特殊结构不包括?EA 荚膜B 鞭毛C 芽胞D 菌毛E 细胞壁13 有关荚膜的描述,错误的为:CA 具有黏附作用B 具有抗吞噬作用C 为细菌的运动细胞器D 在机体内或含动物血清培养基形成E 普通染色不易着色14有关芽胞的描述,错误的为:EA 对外界抵抗力强B 并非所有的细菌都产生芽胞C 能形成芽胞的细菌均为G+菌D 芽孢的形成不是细菌的繁殖方式E 芽孢在机体内或营养丰富的培养基中形成15 细菌繁殖方式为:AA 无性二分裂法B 孢子生殖C 复制D 有丝分裂E 配子生殖16 单个细菌在固体培养基上可形成:CA 菌膜B 沉淀C 菌落D 菌苔E 菌丝17 大多数致病菌最适生生长的温度和PH为:DA 370C,PH6.5~6.8B 250C,PH7.2~7.6C 420C,PH8.4~9.2D 370C,PH7.2~7.6E 560C,PH6.5~6.818 不符合菌落的描述是:AA 在液体培养基中形成B 一个菌落由一个繁殖体形成C 一个菌落包含成千上万个细菌D 肉眼可见E 在固体培养基上形成19 靛基质试验阳性的细菌能分解:CA 含硫氨基酸B 乳糖C 色氨酸D 葡萄糖E 吲哚20 不属于细菌代谢产物的是:EA 毒素B 抗生素C 色素D 热原质E 抗毒素21细菌合成代谢产物有助于细菌鉴别的是:EA 内毒素B 热原质C 抗生素D 维生素E 色素22 关于热原质的描述,错误的是:BA 大多由革兰阴性菌产生B 可被高压蒸汽灭菌破坏C 注入人体或动物体内引起发热反应D 化学成分为一种多糖E 可用吸附剂或过滤等方法除去23 下列细菌中繁殖最慢的是:DA 大肠杆菌B 链球菌C 葡萄球菌D 结核杆菌E 变形杆菌24 药敏试验应选哪个生长期的细菌:BA 稳定期B 对数生长期C 迟缓期D 衰亡期E 稳定后期25杀灭芽孢最有效的方法是:DA 煮沸法B 流通蒸汽法C 巴氏消毒法D 高压蒸汽灭菌法E 煮沸法26乙醇消毒剂常用浓度是:CA 100%B 95%C 70%~75%D 50%E 60%27 对血清培养基的灭菌,应选用:DA 煮沸法B 巴氏消毒法C 流通蒸汽法D 间歇灭菌法E 高压蒸汽灭菌法28 下述不可能杀灭芽孢的方法是:BA 煮沸法B 巴氏消毒法C 干烤D 间歇灭菌法E 高压蒸汽灭菌法29属于氧化剂类的消毒剂是:EA 来苏B 戊二醛C 龙胆紫D新洁尔灭 E 高锰酸钾30 紫外线的杀菌机理为:EA 产生高热B 损伤细胞膜C 产生毒素D 产生热原质E 干扰DNA的正常碱基配对31 一次性注射器、敷料、内镜插管应选用何方法灭菌?CA 煮沸法B 巴氏消毒法C 电离辐射D 间歇灭菌法E 高压蒸汽灭菌法32 紫外线杀菌力最强的波长为(单位nm):BA 248~265B 265~266C 300~400D 180~200E 50033 高压蒸汽灭菌法所用压力及温度分别是:AA 103.4KPa,15~30minB 100KPa,15~30minC 103.4KPa,5~10minD 15KPa,15~30minE 80KPa,15~30min34 正常情况下机体有菌的部位:EA 胃B 骨髓C 肌肉D 血液E 外耳道35 正常菌群引起感染到条件之一是:CA 变为耐药菌B 发生基因突变C 寄居部位改变D 变为L型细菌E 发生S-R变异36 构成细菌毒力的是:DA 基本结构B 特殊结构C 分解代谢产物D 侵袭力和毒素E 侵入机体的途径37 与细菌致病性无关的物质是:DA 毒素B 热原质C 侵袭性酶D 细菌素E 透明质酸酶38 与侵袭力无关的是:DA 荚膜B 菌毛C 血浆凝固酶D 芽孢E 透明质酸酶39 革兰阳性菌具有类似菌毛样作用的成分是:DA 肽聚糖B M蛋白C 脂蛋白D 脂磷壁酸E 壁磷壁酸40内毒素的成分是:BA H抗原B 脂多糖C 荚膜多糖D O抗原E 肽聚糖41 内毒素的毒性成分为:BA 脂多糖B 脂质AC 荚膜多糖D O抗原E 肽聚糖42 外毒素的特点之一为:EA 多由G-菌产生B 多为细菌裂解后释放C 耐热D 化学成分为脂多糖E 可制备成类毒素43 关于内毒素,下列叙述错误的是:DA 来源于G-菌B 化学成分是脂多糖C 耐热D 由活的细菌产生E 不能用甲醛处理脱毒制成类毒素44 下列细菌毒素中,毒性最强的是:AA 肉毒毒素B霍乱肠毒素 C 破伤风痉挛毒素D 白喉外毒素E 伤寒杆菌产生的内毒素45类毒素是:DA 抗毒素经甲醛处理后的物质B 细菌素经甲醛处理后的物质C 维生素经甲醛处理后的物质D 外毒素经甲醛处理后脱毒而保留抗原性的物质E外毒素经甲醛处理后脱毒而改变了抗原性的物质46 下列细菌中,可引起菌血症的是:BA 链球菌B 伤寒沙门菌C 破伤风梭菌D 霍乱弧菌E 肉毒梭菌47 最危险的传染源是:CA 急性期病人B 慢性病人C 带菌者D 有症状的病人E 以上都不对48 关于SPA,下列叙述错误的是:DA 为葡萄球菌的表面蛋白B 具有抗吞噬作用C 能与人IgG的Fc段结合D 所有葡萄球菌均有E 与协同凝集反应有关49 下列对热抵抗力最强的细菌是:EA 伤寒沙门菌B 大肠杆菌C 结核杆菌D 链球菌E 金黄色葡萄球菌50 引起毒性休克综合征的病原菌是:CA 肺炎链球菌B 脑膜炎球菌C 金黄色葡萄球菌D 乙型溶血性链球菌E 甲型溶血性链球菌51葡萄球菌感染病灶容易局限化,是因为该菌产生:CA 杀白细胞素B 透明质酸酶C 血浆凝固酶D 表皮剥脱毒素E 溶血素52 能引起亚急性细菌心内膜炎的细菌为:CA 肺炎链球菌B 表皮葡萄球菌C 甲型溶血性链球菌D 金黄色葡萄球菌E 乙型溶血性链球菌53 能引起人类猩红热的主要毒性物质为:EA 溶血素B 链激酶C 透明质酸酶D M蛋白E 红疹毒素54 A群链球菌产生的致病物质不包括:CA 链激酶B 溶血毒素C 剥脱毒素D 红疹毒素E 透明质酸酶55 下列各项中不属于链球菌致病物质的是:AA 肠毒素B M蛋白C 溶血毒素D 透明质酸酶E 红疹毒素56 肺炎链球菌感染多属于:EA 内源性感染B 外源性感染C 交叉感染D 医源性感染E 继发感染57 肺炎球菌的致病物质主要是:CA 外毒素B 内毒素C 荚膜D 溶血素E M蛋白58 胆汁溶菌试验常用于鉴别:CA 丙型链球菌和淋病奈氏菌B 金黄色葡萄球菌和脑膜炎奈氏菌C 肺炎链球菌和甲型溶血性链球菌D肺炎链球菌和乙型溶血性链球菌E甲型溶血性链球菌和甲型溶血性链球菌59关于脑膜炎奈氏菌的叙述,下列错误的有:BA 为革兰阴性双球菌B 抵抗力较强C 为“流脑”的病原体D 有荚膜和菌毛E 内毒素是其致病主要物质60淋病奈氏菌的主要传播途径是:CA 呼吸道传播B 消化道传播C 性接触传播D 创伤传播E 虫媒传播61 新生儿“脓漏眼”的病原体为:CA 肺炎链球菌B 表皮葡萄球菌C淋病奈氏菌D 金黄色葡萄球菌E 乙型溶血性链球菌62能产生肠毒素,引起食物中毒的球菌为:DA肺炎链球菌 B 表皮葡萄球菌C淋病奈氏菌D 金黄色葡萄球菌E 乙型溶血性链球菌63.关于肠道杆菌生物学特性描述错误的是:AA 革兰阳性B 大多是肠道中正常菌群C 革兰阴性短小杆菌D 不形成芽胞E 仅靠形态、染色性不易区别64.下列细菌动力试验阴性的是:CA 大肠杆菌B 伤寒杆菌C 痢疾杆菌D 副伤寒杆菌E 甲型副伤寒杆菌65.肥达试验的原理是:AA 试管凝集试验B 沉淀反应C 中和反应D 酶联免疫技术E 玻片凝集试验66.外斐反应可协助诊断下列何种疾病:CA 伤寒B 副伤寒C 立克次体病D 细菌性痢疾E 急性肾小球肾炎67.肠道杆菌中可分解乳糖产酸产气的是:AA 大肠杆菌B 痢疾杆菌C 副伤寒杆菌D 伤寒杆菌E 甲型副伤寒杆菌68 鉴别肠道致病菌与非致病菌常选用:CA 吲哚试验B 菊糖发酵试验C 乳糖发酵试验D 甘露醇试验E 葡萄糖发酵试验69 痢疾患者的粪便标本进行分离、培养应选用:EA 肉汤培养基B 血平板C 葡萄琼脂平板D 厌氧培养基E SS平板70 下列细菌中,不能引起败血症的细菌有:CA 大肠埃希菌B 肠炎沙门菌C 痢疾志贺菌D 变形杆菌E 丙型副伤寒沙门菌71 下列细菌中,可引起菌血症的细菌有:EA 霍乱弧菌B 肠炎沙门菌C 大肠埃希菌D痢疾志贺菌 E 伤寒沙门菌72 有迁徙现象的细菌是:DA 大肠埃希菌B 肠炎沙门菌C 痢疾志贺菌D 变形杆菌E 丙型副伤寒沙门菌73 肠道杆菌的微生物学检查中,下列哪项无鉴别意义?DA 生化试验B 血清学试验C 细菌分离培养D 形态学检查E 动力试验74 临床症状出现发热、里急后重,并有脓血黏液粪便,可能哪种细菌引起?CA 霍乱弧菌B 肠炎沙门菌C 痢疾志贺菌D 金黄色葡萄球菌E副溶血性弧菌75预防接种伤寒菌苗或非特异性回忆应答可出现:AA H抗体高于正常值,O抗体低于正常值B H抗体效价和O抗体效价均高于正常值C H抗体效价和O抗体效价均低于正常值D H抗体低于正常值,O抗体高于正常值E 以上均不是76 关于霍乱弧菌生物学特性的叙述,错误的有:DA 氧化酶试验为阳性B 标本作悬滴法,可见“鱼群样穿梭”C 耐碱不耐酸D 有菌毛和荚膜E 革兰阴性弧菌,有单鞭毛77 关于霍乱肠毒素,下列哪项正确?CA 为耐热内毒素B 为耐热外毒素C 由A、B 两个亚单位组成D A亚单位与细胞受体结合E B亚单位进入细胞内发挥毒性作用78 我国沿海地区食物中毒最常见的一种病原菌是:AA 副溶血性弧菌B 痢疾杆菌C 金黄色葡萄球菌D 变形杆菌E 破伤风杆菌79 霍乱肠毒素的作用机理是:BA 作用鸟苷酸环化酶B作用腺苷酸环化酶C 刺激呕吐中枢D 作用肠壁植物神经E 抑制蛋白质合成中的延长因子80破伤风梭菌的致病因素是:DA 溶血毒素B 红疹毒素C 肠毒素D 痉挛毒素E 内毒素81破伤风梭菌的致病因素是:DA 溶血毒素B 红疹毒素C 肠毒素D 痉挛毒素E 内毒素82 为预防破伤风应注射:CA 破伤风减毒活菌苗B 破伤风死菌苗C 破伤风类毒素D 破伤风外毒素E 丙种球蛋白83 下列毒素毒性最强的是:BA 破伤风毒素B 肉毒毒素C 肠毒素D 红疹毒素E 内毒素84 下列细菌不侵入血流的是:DA 金黄色葡萄球菌B 脑膜炎奈瑟菌C 伤寒杆菌D 破伤风梭菌E 链球菌85 新生儿因断脐时使用未彻底灭菌的接生用具,可发生:BA 肉毒中毒B 破伤风C 痢疾D 坏死性肠炎E 猩红热86 有关结核分支杆菌生物学特性描述错误的是:BA 菌体细长略弯曲B 培养24小时后观察菌落C 对干燥抵抗力强D 对紫外线敏感E 对酸碱有一定的耐受性87 采用何种最佳方法检测人体对结核杆菌具有免疫力:DA 直接涂片B 分离培养C 动物试验D 结核菌素试验E 暗视野显微镜检查88 OT试验的原理是:DA I型变态反应B II型变态反应C III型变态反应D IV型变态反应E 以上都不对89 下列疾病通过吸血昆虫作为媒介传播的是:DA 白喉B 炭疽C 百日咳D 鼠疫E 伤寒90.波浪热由下列哪种病原菌引起:AA 布鲁杆菌B 空肠弯曲菌C 鼠疫杆菌D 绿脓杆菌E 大肠杆菌91下列哪种细菌不属于动物源性细菌:DA 小肠结肠炎耶森菌B 炭疽杆菌C 鼠疫杆菌D 绿脓杆菌E 布氏菌属92 培养时需厌氧环境的细菌是:EA 绿脓杆菌B 鼠疫杆菌C 变形杆菌D 伤寒沙门菌E 脆弱类杆菌93 无芽孢厌氧菌感染中,最常见的是:AA 脆弱类杆菌B 产黑色素类杆菌C 消化链球菌属D 乳酸杆菌属E 双歧杆菌属94 破伤风的紧急预防应注射:CA 类毒素B 抗生素C 抗毒素D 干扰素E 丙种球蛋白95 引起气性坏疽的主要病原菌是:EA 炭疽杆菌B 变形杆菌C 产气杆菌D 鼠疫杆菌E 产气荚膜梭菌96可引起食物中毒的病原菌是:EA炭疽杆菌 B 破伤风梭菌 C 产黑色素杆菌D 脆弱类杆菌E 产气荚膜梭菌97 “汹涌发酵”现象是用于鉴定:EA 炭疽杆菌B 破伤风梭菌C 产黑色素杆菌D 脆弱类杆菌E 产气荚膜梭菌98 毒素的产生与前噬菌体有关的细菌是:EA 霍乱弧菌B 破伤风梭菌C 大肠杆菌D 结核杆菌E 白喉棒状杆菌99结核分枝杆菌常用哪种培养基培养?BA 沙保培养基B 罗氏培养基C 庖肉培养基D 巧克力色培养基E 亚碲酸钾培养基100 与结核分枝杆菌抗酸性密切相关的成分是:CA 磷脂B 蜡质DC 分枝菌酸D 索状因子E 硫酸脑苷脂101 不产生内、外毒素的细菌有:EA 绿脓杆菌B 炭疽杆菌C 布氏杆菌D 白喉棒状杆菌E 结核分枝杆菌102 放线菌与结核分枝杆菌的区别是:BA 革兰染色阳性B 抗酸染色阴性C 菌体细长有分枝D 菌落为R型E 对抗生素敏感103 放线菌引起的化脓性感染其脓液特征是:EA 粘稠,呈金黄色B 稀薄,呈血水样C 稀薄,呈蓝绿色D 稀薄,呈暗黑色E 脓液中可见硫磺颗粒104 衣氏放线菌引起的化脓性感染类型属于:DA 急性感染B 隐性感染C 外源性感染D 内源性感染E 接触感染105 对炭疽杆菌致病性的叙述,下列错误的有:DA 荚膜的抗吞噬作用使该菌易于在体内生长B 炭疽毒素由三种成分组成C 其毒素易发生DIC和感染性休克D 组成毒素的三种成分可以各自独立发挥毒性作用E 炭疽毒素主要损害微血管的内皮细胞106 对嗜肺军团菌致病性叙述下列错误的是:CA 通过呼吸道侵入机体B 其胞内寄生性是重要的致并因素C 通过荚膜抗吞噬致病D 军团病有肺炎型和流感伤寒型两种类型E 机体免疫力低下是发病的重要因素107 下列哪种是条件致病菌?BA 伤寒沙门菌B 绿脓杆菌C 霍乱弧菌D 破伤风梭菌E 结核分枝杆菌108下列细菌中,引起婴幼儿急性肠炎的常见细菌是:DA 霍乱弧菌B 伤寒沙门菌C 痢疾志贺菌D 空肠弯曲菌E 绿脓杆菌109 与B型胃炎、胃和十二指肠溃疡密切相关的是:BA霍乱弧菌 B 幽门螺杆菌 C 痢疾志贺菌D 空肠弯曲菌 E 绿脓杆菌110梅毒由下列哪种病原菌引起:DA 肺炎支原体B 沙眼衣原体C 立克次体D 螺旋体E 细菌111 接触疫水疫土而感染的病原微生物是:DA 支原体B 衣原体C 普氏立克次体D 钩端螺旋体E 放线菌112外—斐反应可协助诊断下列哪种疾病:BA 沙眼B 立克次体病C 梅毒D 原发性非典型肺炎E 细菌性痢疾113 介于病毒与细菌之间的原核细胞型微生物是:AA 立克次体B 螺旋体C 支原体D 放线菌E 真菌114能够在无生命培养基上生长繁殖的最小的原核细胞型微生物是:CA 脑膜炎球菌B 钩端螺旋体C 肺炎支原体D 放线菌E 病毒115 原发性非典型肺炎最常见的微生物是:CA 细菌B 冠状病毒C 支原体D 螺旋体E 肺炎链球菌116 地方性斑疹伤寒的传播媒介是:CA 蜱B 蚊C 鼠蚤D 恙螨E 鼠虱117 下列疾病中由立克次体引起的有:DA 梅毒B 沙眼C 细菌性痢疾D 恙虫病E 性病淋巴肉芽肿118 有独特发育周期的微生物是:DA 立克次体B 螺旋体C 支原体D 衣原体E 病毒119 衣原体与病毒的相似点是:EA 含两类核酸B 有核蛋白体C 二分裂繁殖D 对多种抗生素敏感E 专性活细胞内寄生120 真菌细胞壁特有的成分是:BA 肽聚糖B 几丁质C 胆固醇D 磷脂E 角质121 下列哪项不是真菌产生的孢子?EA 大分生孢子B 小分生孢子C 厚膜孢子D 芽生孢子E 腐生孢子122多细胞真菌的菌落类型是:CA 酵母型菌落B 类酵母型菌落C 丝状菌落D 类丝状型E 混合型菌落123 一般浅部真菌生长的最适温度是:BA 20~250CB 22~280C C 30~320CD 34~360CE 35~370C124 深部感染真菌的最适生长温度是:EA 250CB 280C C 300CD 330CE 370C125真菌在不利环境中形成哪种孢子?CA 大分生孢子B 小分生孢子C 厚膜孢子D 芽生孢子E 腐生孢子126 真菌的致病不包括:EA 毒素中毒B 变态反应性疾病C 条件致病性真菌感染D 毒素的致癌作用E 产生神经氨酸酶127 黄曲霉毒素与哪种肿瘤关系最密切?AA 肝癌B 食管癌C 结肠癌D 肺癌E 神经胶质瘤128 关于皮肤癣菌的描述,错误的是:CA 引起局部炎症和病变B 具有嗜角质性C 其致是因为产生外毒素D 为多细胞真菌E 通过机械性刺激和代谢产物的作用致病129 检查新型隐球菌常用的染色方法是:CA 革兰染色B 抗酸染色C 墨汁染色D 美兰染色E 镀银染色130 病毒体为:AA 核心+衣壳B 衣壳+胞膜C 核衣壳+胞膜D 核心+刺突E 胞膜+刺突131 大多数病毒的形态为:AA 球形B 蝌蚪形C 弹头状D 砖形E 丝状132病毒的基本性状中不包括:EA 专性细胞内寄生B 只含有一种核酸C 可通过滤菌器D 结构简单,非细胞型微生物E 营养要求高,在血清培养基上可生长133 病毒蛋白的作用不包括:DA 保护B 吸附C 免疫原性D 被脂溶剂破坏E 构成衣壳的成分134 病毒复制周期中隐蔽期是指下列哪个阶段?DA 吸附B 穿入C 脱壳D 生物合成E 成熟组装135下列病毒个体最大,在光学显微镜下观察到?DA 脊髓灰质炎病毒B 乙型肝炎病毒C 乙脑病毒D 痘类病毒E 狂犬病毒136 病毒的增殖方式为:AA 复制B 配子生殖C 无性二分裂法D 有丝分裂E 芽孢形成137病毒感染性核酸指:DA 带有衣壳的核酸B 脱去衣壳的核酸C 可直接作为mRNA的核酸D 进入细胞并能复制的核酸E 带有逆转录酶的核酸138 有胞膜的病毒侵入细胞的方式是:EA 胞饮B 直接穿入C 裂解细胞膜D 吞噬E 胞膜与细胞膜融合139 关于病毒在宿主细胞内复制周期过程,正确的是:AA 吸附、穿入、脱壳、生物合成、装配与释放B 吸附、脱壳、生物合成、装配与释放C 吸附、接合、穿入、生物合成、装配与释放D吸附、穿入、生物合成、装配与释放E 结合、穿入、脱壳、生物合成、装配与释放140 下列哪组病毒易发生潜伏感染?AA 水痘、单纯疱疹VB 水痘、乙型脑炎VC 水痘V和HBVD 单纯疱疹V、HBVE 单纯疱疹V与乙型脑炎V 141 可引起慢发病毒感染的是:AA 麻疹病毒B 甲型肝炎病毒C 流行性感冒病毒D 水痘带状疱疹病毒E 单纯疱疹病毒142 中和抗体对病毒的作用机理是:EA 诱导干扰素产生B 杀伤细胞内的病毒C 直接杀伤细胞外的病毒D 抑制病毒的生物合成E 阻止病毒体吸附并侵入易感细胞143 关于干扰素的下列描述,错误的是:AA 可直接作用于病毒B 抗病毒作用有相对的种属特异性C 有广谱抗病毒活性D 有调节免疫的功能E 有抑制肿瘤细胞生长的作用144 潜伏感染时,在发作的间隙:AA 不能分离出病毒B 可以分离出病毒C 间歇分离出病毒D 分离不到病毒,也测不到抗体E 分离出病毒,但测不到抗体145 参与抗病毒特异性免疫中,作用最强的是:EA 巨噬细胞B 单核细胞C NK细胞D 中性粒细胞E 细胞毒T细胞146 关于病毒的致病机制,下列哪项错误?EA 杀细胞感染B细胞膜发生融合 C 包涵体形成D 细胞遗传性状改变E 病毒合成侵袭性酶类溶解宿主细胞147 下列何种药物不是抗病毒药物?EA 干扰素B 无环鸟苷C 病毒唑D 叠氮胸苷E 头孢菌素148关于病毒抵抗力特点叙述错误的是:DA 560C、30分钟多数病毒灭活B 有胞膜病毒对脂溶剂敏感C 50%甘油盐水保存病毒标本D 被细菌污染病毒标本可用病毒唑处理E无胞膜的病毒对脂溶剂有抗性149 构成病毒核心的成分为:DA 蛋白质B 磷酸C 类脂D 核酸E 肽聚糖150 引起流感世界性大流行的病原体是:BA 流感杆菌B 甲型流感病毒C 乙型流感病毒D 丙型流感病毒E 副流感病毒151 对甲型流感病毒抗原转变的错误叙述是:DA HA和NA变异幅度大B 属于质变C 产生流感内病毒新亚型D 由病毒基因点突变造成E 由不同型别的流感病毒基因重组造成152 流感病毒分型的依据是:EA 所致疾病的临床特征B 流行病学特征C 血凝素D 神经氨酸酶E 核蛋白抗原和M蛋白不同153 下列病毒感染机体可获得终生免疫除哪种病毒外?CA 腮腺炎病毒B 脊髓灰质炎病毒C 甲型流感病毒D 麻疹病毒E 流行性乙型脑炎病毒154 亚急性硬化性全脑炎的病原体是:DA 脊髓灰质炎病毒B 腮腺炎病毒C 流行性感冒病毒D 麻疹病毒E 狂犬病毒155 下列病毒感染多为隐性感染除哪种病毒以外?BA 疱疹病毒B 麻疹病毒C 乙型脑炎病毒D HA VE 脊髓灰质炎病毒156 引起婴幼儿下呼吸道感染最常见的病毒是:EA 腺病毒B 流感病毒C 麻疹病毒D 腮腺炎病毒E 呼吸道合胞病毒157可通过垂直传播引起胎儿畸形的呼吸道病毒是:CA 麻疹病毒B 流感病毒C 风疹病毒D 腮腺炎病毒E 呼吸道合胞病毒158 肠道病毒共同特性中,下列叙述错误的是:DA 耐酸、耐乙醚B 球形的病毒C 通过“粪-口”途径传播D 有包膜E 基因组为单股正链RNA159 脊髓灰质炎病毒致病特点不包括:DA 经“粪-口”途径传播B 两次病毒血症C 多为隐性感染D 5岁以下幼儿易感染E 病后获得同型病毒牢固到免疫力160婴幼儿急性胃肠炎最重要的病原体为:DA 柯萨奇病毒B 埃可病毒C 肠道腺病毒D 轮状病毒E Norwall病毒161 核酸类型为单股负链RNA的肝炎病毒为:DA HA VB HBVC HCVD HDVE HEV162下列病毒中,属于辅助病毒的是:DA HA VB HBVC HCVD HDVE HEV163目前可通过接种减毒活疫苗预防的肝炎病毒为:AA HA VB HBVC HCVD HDVE HEV164 HA V的主要传播途径为:EA 输血、注射B 母婴垂直传播C 虫媒传播D 接触传播E 粪-口途径传播165Dane颗粒是:BA 乙肝病毒的小球形颗粒B乙肝病毒的大球形颗粒C乙肝病毒的管型颗粒 D 流感病毒体 E EB 病毒体166 下列物质中,具有感染性的是:CA 管型颗粒B 小球型颗粒C Dane颗粒D HBcAgE HbeAg167血液中检测不到的是:CA HBsAgB HBeAgC HBcAgD 抗-HBsE 抗-HBe168 具有高度传染性的HBV感染者血液中可检测到:CA HBsAg HBcAg HBeAgB HBsAg 抗-HBe 抗-HBcC HBsAg 抗-HBc HBeAgD 抗-HBe 抗-HBc HBsAgE HBsAg 抗-HBc HBcAg169 对乙型肝炎的错误叙述是:DA 感染途径主要是血源性B 人感染后可表现为无症状抗原携带者C 有些可以发展成为肝硬化或肝癌D HBV其杀伤机理为直接杀细胞效应170 不必接受HBsIg被动免疫的人群为:CA HBsAg阳性母亲所生新生儿B 输入了HBsAg阳性血液者C 无症状HBsAg携带者D 接受了HBsAg阳性器官的移植者E 体表破损处沾染了HBsAg阳性血清者171 下列方法中不能灭活HBV的是:BA 煮沸1000C,30minB 紫外线C 0.5%过氧乙酸D 1210C,20minE 干热1600C,1h172HCV最主要的传播途径是:EA 消化道B 日常生活接触C 性接触D 母婴垂直传播E 血液和血制品173 目前控制HCV传播的主要措施是:EA 接种疫苗B 注射丙种球蛋白C 注射干扰素D 注射高效价免疫血清E 对献血员进行抗-HCV 筛选174 δ因子是指:DA HA VB HBVC HCVD HDVE HEV175 孕妇感染后发病率高、病情严重的是:E。

肠道细菌的实验报告引言肠道细菌是人体消化道中存在的微生物,对人体健康和免疫功能具有重要作用。
本实验旨在通过培养和研究肠道细菌,了解其特性和影响因素,为进一步研究肠道健康提供科学依据。
实验方法实验材料1. 肠道细菌样本(人体粪便样本)2. 营养琼脂培养基3. 石蜡瓶4. 培养皿5. 无菌试管、噻唑蓝试剂6. 实验室标准设备和仪器实验步骤1. 用无菌试管采集肠道细菌样本,并在无菌条件下将其转移到石蜡瓶中。
2. 在培养皿中加入营养琼脂培养基,石蜡瓶中的肠道细菌样本均匀涂抹在培养皿上。
3. 将培养皿置于恒温培养箱中,以37摄氏度培养24小时。
4. 观察培养皿中的细菌生长情况,并记录结果。
实验结果经过24小时培养,我们观察到培养皿中出现了多种不同形态和颜色的细菌。
其中,主要观察到以下几种常见肠道细菌:1. 大肠杆菌(Escherichia coli):呈现圆形、鲜亮的橙红色菌落。
2. 肠球菌(Enterococcus faecalis):呈现小形或中形、呈黄色或乳白色菌落。
3. 梭状芽胞杆菌(Clostridium difficile):呈现长条形的白色菌落。
4. 腺病毒(Adenovirus):呈现透明的圆形菌落。
讨论与分析肠道细菌是人体肠道内的共生微生物,在人体的消化和免疫功能中起着重要作用。
此次实验观察到的肠道细菌具有多样性,这与人体消化道中存在的多种微生物种类相符。
其中,大肠杆菌和肠球菌是人体肠道中最常见的细菌,其在人体内的生存和繁殖与人体健康密切相关。
肠道细菌的种类和数量对人体健康有重要影响。
正常肠道菌群的稳定和平衡与人体的免疫功能、营养代谢和防病能力密切相关。
一些研究发现,肠道细菌的失调可能与多种疾病的发生和发展有关,如肠道炎症、肠道肿瘤和肠易激综合征等。
结论通过这次实验,我们成功培养出了肠道细菌样本,并观察到了不同菌种的生长情况。
肠道细菌的多样性和数量对人体健康具有重要影响,进一步研究肠道菌群的组成和功能,有助于理解人体免疫和消化系统的运作机制,为肠道健康的保护和促进提供科学依据。

食品中的常见致病菌分析在我们日常生活中,食品安全一直是人们关注的焦点之一。
食品污染问题严重影响着公众的健康。
其中一个主要的原因是由于存在于食品中的致病菌。
本文将对食品中常见的致病菌进行分析,以加深我们对相关风险与危害的认识,并探讨如何预防和控制这些致病菌。
一、肠道致病菌肠道是许多细菌栖息和滋生的环境,其中有些种类可以引起食物中毒或感染性胃肠炎。
常见的肠道致病菌包括沙门氏菌、大肠杆菌等。
1. 沙门氏菌沙门氏菌是一种广泛存在于自然界及动物体内的革兰阴性杆菌,可通过受污染的饮食而感染人类。
其主要来源为家禽、牛奶、蛋制品以及其他动物产品。
患者会呈现发热、腹泻等症状,严重者可能导致败血症、休克甚至死亡。
沙门氏菌感染的主要途径是摄入受污染的食物或水。
2. 大肠杆菌大肠杆菌是一种常见的细菌,大部分对人体无害。
然而,某些毒性变种如大肠杆菌O157:H7等可引起严重的食物中毒。
这些变种通常来源于被污染的牛奶、牛羊肉以及果蔬等。
大肠杆菌感染会导致腹泻、呕吐、腹痛等胃肠道症状,有时也伴随发热。
严重者可能引发溶血性尿毒综合征(HUS)等并发症。
二、食源性许多其他致病菌除了上述肠道致病菌外,还存在许多其他种类的致病菌,它们通过不同的方式危害着人们的健康。
1. 金黄色葡萄球菌金黄色葡萄球菌广泛存在于自然界中,特别是在动物和人身上皮肤及黏膜组织表面。
致病性的金黄色葡萄球菌主要通过食物污染引起中毒。
储存不当的食品、受到感染者接触的食品以及不洁卫生条件下加工制作的食品都可能被金黄色葡萄球菌污染。
其感染会引起急性呕吐、腹痛和腹泻等中毒症状,但多数病情较轻并自行恢复。
2. 嗜肺军团菌嗜肺军团菌是一种能够在淡水环境或设备上栖息并增殖的细菌,通常与人类活动相关。
最为严重的感染途径是通过吸入由带有细菌的水雾所产生的气溶胶。
嗜肺军团菌感染导致军团病,临床表现为高热、头痛、咳嗽等,并可能引发肺部和全身器官损伤。
该细菌常出现于供应水源、空调系统以及其他水处理系统中。

肠道杆菌(enteric bacilli )是一大群寄居在人和动物肠道中生物学形状近似的G -杆菌。
如:大肠杆菌,肠道致病菌(伤寒杆菌、痢疾杆菌、变形杆菌等)(一)SS 平板一种强选择性培养基。
主要成分为营养物质、抑菌物质、促进待检菌生长的物质及指示剂(指示剂为中性红:酸红,碱黄)等。
乳糖被非致病菌分解产酸,蛋白胨被致病菌分解产碱。
大肠杆菌形成分解乳糖,呈红色菌落。
而肠道致病菌不分解乳糖,菌落呈透明微黄色。
乳糖发酵试验:大肠杆菌菌落大,分解乳糖——“大红” 肠道致病菌菌落小,不分解乳糖——“小白” (二)双糖铁培养基用于观察细菌是否产生硫化氢及对糖的发酵能力,初步鉴别细菌。
此培养基上层含乳糖、酚红、硫酸亚铁,固体斜面;下层含葡萄糖、酚红,半固体(可以观察细菌是否运动——是否有鞭毛)。
大肠杆菌能发酵乳糖和葡萄糖产酸产气,使斜面与底层均呈黄色并有气泡。
而肠道致病菌一般只发酵葡萄糖不发酵乳糖,故底层为黄色;上层因接触空气而氧化,并因细菌生长繁殖会生成碱性化合物,使斜面部分变为红色。
(指示剂为酚红)(三)糖发酵试验酸性复红为指示剂,若能分解糖,则变红。
内置一小试管,以便收集气体。
(四)靛基质(吲哚)生成试验具有色氨酸酶的细菌能够分解蛋白胨中的色氨酸形成靛基质,试剂中的对二甲基氨基苯甲醛(油性,浮于液面)与靛基质结合形成玫瑰色靛基质,容易识别。
血清学鉴定SS 培养基等分离培养粪便或肛拭子双糖铁培养基上、下层均发酵 (大肠杆菌)生化反应下层发酵、上层不发酵 (可疑肠道致病菌)将试验菌接种在蛋白胨水肿,37℃温箱培养24h后取出,加入柯氏试剂2~3滴,震荡后两者接触面呈玫瑰色为阳性,黄色为阴性。
(五)尿素分解试验又有尿素酶的细菌能够分解尿素产生氨,使培养基pH上升,酚红指示剂变为红色。
将试验菌接种到尿素固体培养基上,37℃温箱培养18~24h,培养基呈红色为阳性。
霍乱弧菌G-;菌体呈弧形或逗点状(一个弯曲);一端有单鞭毛,有些菌株有荚膜。

肠道杆菌、厌氧性细菌、分枝杆菌(本科)试卷及答案基本信息:[矩阵文本题] *1.下述正确的为(2010年执业医师考题)()。
[单选题] *A.A群一痢疾志贺菌B.B群一福氏志贺菌C.C群一鲍氏志贺菌D.D群一宋内志贺菌E.以上均正确(正确答案)2.下列关于肠道杆菌的叙述,错误的是(2013年执业医师考试模拟题) ()。
[单选题] *A.G-中等大小杆菌B.抗原结构复杂,是分类依据C.生化反应活泼,都能分解乳糖产酸(正确答案)D.多数有鞭毛E.多数为条件致病菌,少数为致病菌3.初步鉴别肠道杆菌有无致病性的重要依据是(2013年执业医师考试模拟题) ()。
[单选题] *A.葡萄糖发酵试验B.乳糖发酵试验(正确答案)C.硫化氢试验D.甲基红试验E.吲哚试验4.肠道杆菌不具备的抗原是(2013年执业医师考试模拟题 ) ()。
[单选题] *A.Vi抗原B.H抗原C.O抗原D.M抗原(正确答案)E.K抗原5.在引起腹泻的大肠埃希菌中,能产生志贺样毒素的是(2013年执业医师考试模拟题) ()。
[单选题] *A.EPECB.EAECC.ETECD.EIECE.EHEC(正确答案)6.与痢疾志贺菌致病性相关的物质有(2013年执业医师考试模拟题) ()。
[单选题] *A.外毒素B.侵袭性酶类C.内毒素D.内毒素和外毒素(正确答案)E.霍乱肠毒素7.某患者因近3日腹泻腹痛前来就诊。
自述有里急后重感,便内有脓血,疑似痢疾。
试问如进一步确诊进行微生物学检查时,一般不做哪些检查? (执业医师考试模拟题) ()。
[单选题] *A.血清学鉴定B.生化反应C.直接涂片革兰染色查形态(正确答案)D.免疫荧光菌球试验E.检测细菌核酸8.与志贺毒素致病作用类似的毒素是【历年考题点津】()。
[单选题] *A.肉毒外毒素B.大肠杆菌内毒素C.霍乱外毒素(正确答案)D.金葡菌外毒素E.伤寒杆菌内毒素9.关于痢疾杆菌【历年考题点津】()。

试谈肠道致病菌的检验与鉴定1. 背景介绍肠道致病菌是指寄生在人体肠道内能够引起疾病的细菌。
这些致病菌能够通过进食受污染的食物或水源进入人体,引发各种肠道感染和疾病,如腹泻、呕吐、腹痛等。
因此,对肠道致病菌进行准确的检验与鉴定对于控制肠道传染病的流行具有重要意义。
本文将介绍肠道致病菌的常见检验方法和鉴定技术。
2. 肠道致病菌的常见检验方法2.1 培养法培养法是目前最常用的肠道致病菌检验方法之一。
它基于菌落形态、生理生化特性和生长要求的差异来区分不同的细菌。
常用的培养基有MacConkey培养基、Eosin Methylene Blue (EMB) 培养基等。
通过将肠道样本划线接种于培养基上,利用菌落形态和生长特性,可以初步鉴定肠道细菌的种类。
2.2 免疫学检验法免疫学检验法基于肠道致病菌与人体免疫系统的相互作用,通过检测体液中特定的抗体或抗原来判断致病菌的存在。
常用的免疫学检验方法包括酶联免疫吸附试验(ELISA)和免疫荧光法等。
这些方法具有操作简便、高灵敏度和高特异性的特点,因此在临床上得到广泛应用。
2.3 分子生物学检验法分子生物学检验法是近年来快速发展的肠道致病菌检验方法之一。
它通过检测肠道菌株的DNA或RNA序列来鉴定菌株的种类和特性。
常用的分子生物学检验方法包括聚合酶链反应(PCR)和DNA测序等。
这些方法具有高度的灵敏度和特异性,可以准确鉴定肠道致病菌的种类,对于快速诊断和追踪肠道感染具有重要意义。
3. 肠道致病菌的鉴定技术3.1 生物化学鉴定生物化学鉴定是一种基于菌落形态、氧要求、生理代谢等特性来鉴定肠道致病菌的技术。
通过对菌株进行一系列的生化试验,如某些酶的活性检测、糖和氨基酸的利用等,可以确定菌株的身份。
这种方法操作相对简单,但存在一定的误差和局限性。
3.2 分子生物学鉴定分子生物学鉴定是目前最常用的肠道致病菌鉴定技术之一。
通过检测菌株的基因组序列、DNA指纹图谱等,可以准确鉴定菌株的种类和亚型。

病原性细菌一、单项选择题1、葡萄球菌生物学性状不包括()A、革兰染色阳性B、有透明质酸组成的荚膜C、无鞭毛D、可产生脂溶性色素E、不形成芽胞2、金黄色葡萄球菌的血浆凝固酶可以()A、促进细菌在体内扩散B、由表皮葡萄球菌产生C、增强细菌抗吞噬能力D、能与抗体IgG的Fab段非特异性结合E、水解透明质酸3、金黄色葡萄球菌的致病因素不包括()A、葡萄球菌溶素B、血浆凝固酶C、肠毒素D、菌毛E、表皮剥脱毒素4、致病性葡萄球菌的重要鉴定依据不包括()A,金黄色色素B、血平板上溶血C、凝固酶阳性D、能分解葡萄糖E、能分解甘露醇5、金黄色葡萄球菌引起的毒素性疾病不包括()A、猩红热B、烫伤样皮肤综合征C、假膜性肠炎D、毒性休克综合征E、食物中毒6、使金黄色葡萄球菌在血平板上产生透明溶血环的是()A、血浆凝固酶B、杀白细胞素C、葡萄球菌溶素D、透明质酸酶E、溶菌酶7、可引起毒性休克综合征的病原菌是()A、肺炎链球菌B、脑膜炎奈氏菌C、金黄色葡萄球菌D、甲型溶血性链球菌E、乙型溶血性链球菌8、链球菌的分类依据之一是()A、能否产生血浆凝固酶B、产生色素的颜色不同C、鞭毛抗原的不同D、在血平板中的溶血现象不同E、传播途径不同9、对人有致病性的链球菌主要是()A、A族链球菌B、B族链球菌C、D族链球菌D、C族链球菌E、E族链球菌10、乙型溶血性链球菌引起的疾病不包括()A、猩红热B、亚急性细菌性心内膜炎C、中耳炎D、风湿热E、链球菌感染后球肾炎11、能引起亚急性细菌性心内膜炎最常见的病原菌是()A、乙型溶血性链球菌B、脑膜炎奈瑟菌C、金黄色葡萄球菌D、甲型溶血性链球菌E、肺炎链球菌12、乙型溶血性链球菌的致病物质不包括()A、肠毒素B、M蛋白C、链球菌溶素D、透明质酸酶E、致热外毒素13、抗链O试验检测的是()A、M蛋白B、溶血素OC、溶血素SD、抗溶血素O抗体E、抗溶血素S抗体14、治疗链球菌感染首选的抗生素是()A、黄连素B、氯霉素C、利福平D、青霉素E、氯霉素15、耐酸耐碱的细菌是( )A.霍乱弧菌B.志贺氏菌C.结核分枝杆菌D.副溶血性弧菌E.军团菌16、与胃溃疡有关的细菌是( )A.空肠弯曲菌B.志贺氏菌C.结核分枝杆菌D.军团菌E.幽门螺杆菌17、肺炎链球菌引起的感染常为()A、内源性感染B、外源性感染C、医源性感染D、交叉感染E、继发感染18、脑膜炎奈瑟菌的主要致病物质是()A、荚膜B、菌毛C、内毒素D、自溶酶E、红疹毒素19、淋病奈瑟菌可引起()A、性病淋巴肉芽肿B、包涵体结膜炎C、脓漏眼D、沙眼E、青光眼20、直接涂片镜检检测淋病奈瑟菌时,最常用的标本是()A、泌尿生殖道的脓性分泌物B、皮肤的出血瘀斑渗出物C、脑脊液D、呕吐物或剩余食物E、伤口坏死组织或渗出物21、下列那个细菌对热的抵抗力最强()A、伤寒沙门菌B、大肠埃希菌C、脑膜炎奈瑟菌D、葡萄球菌E、霍乱弧菌22、与链球菌所致的超敏反应性疾病有关的致病物质是()A、链激酶B、透明质酸酶C、链球菌溶素D、M蛋白E、链道酶23、鉴别肠道致病菌与非致病菌的初步试验常选用()A、吲哚试验B、尿素水解试验C、乳糖发酵试验D、H2S试验E、胆汁溶菌试验24、结核分枝杆菌与致病有关的是( )A.内毒素B.菌体成分C.外毒素D.侵袭性酶类E.菌毛25、烧伤病人常继发感染的细菌是( )A.铜绿假单胞菌B.百日咳鲍特氏菌C.流感嗜血杆菌D.军团菌E.乙型溶血性链球菌26、结核分枝杆菌常用的染色法是( )A.革兰氏染色B.抗酸染色C.镀银染色D.瑞氏染色E.墨汁染色27、下列肠道杆菌中有胞内寄生特点的是()A、大肠埃希菌B、痢疾志贺菌C、伤寒沙门菌D、变形杆菌E、肺炎克雷伯菌28、主要引起肠外感染的肠道杆菌是()A、普通大肠埃希菌B、痢疾志贺菌C、伤寒沙门菌D、致病性大肠埃希菌E、甲型副伤寒沙门菌29、在致病过程中,常引起两次菌血症的细菌是()A、大肠埃希菌B、伤寒沙门菌C、霍乱弧菌D、肠炎沙门菌E、痢疾志贺菌30、感染后患者的免疫以细胞免疫为主的致病菌是()A、大肠埃希菌B、痢疾志贺菌C、伤寒沙门菌D、变形杆菌E、霍乱弧菌31、白喉杆菌毒素特点中的错误是()A.干扰细胞蛋白质合成,引起细胞坏死B.溶原性白喉杆菌为产毒株C.毒素耐热D.治疗应早期用抗毒素中和毒素E.易作用于心肌32、引起细胞免疫为主的人畜共患菌是()A.布氏杆菌B.伤寒杆菌C.结核杆菌D.麻风杆菌E.军团菌33、伤寒沙门菌的鞭毛为()A、单端单生鞭毛B、两端单生鞭毛C、单端丛生鞭毛D、两端丛生鞭毛E、周生鞭毛34、临床症状可引起霍乱样腹泻的大肠埃希菌是()A、肠产毒型大肠埃希菌(ETEC)B、肠致病型大肠埃希菌(EPEC)C、肠侵袭型大肠埃希菌(EIEC)D、肠出血型大肠埃希菌(EHEC)E、肠集聚型大肠埃希菌(EaggEC)35、主要引起旅游者和婴幼儿腹泻的细菌是()A、肠产毒型大肠埃希菌(ETEC)B、肠致病型大肠埃希菌(EPEC)C、肠侵袭型大肠埃希菌(EIEC)D、肠出血型大肠埃希菌(EHEC)E、肠集聚型大肠埃希菌(EaggEC)36、一般不能引起败血症的细菌是( )A、大肠埃希菌B、肠炎沙门菌C、痢疾志贺菌D、变形杆菌E、沙寒沙门菌37、在我国感染率最高,且易转为慢性的志贺菌是( )A、A群志贺菌(痢疾志贺菌)B、B群志贺菌(福氏志贺菌)C、C群志贺菌(鲍氏志贺菌)D、D群志贺菌(宋内志贺菌)E、以上都是38、霍乱弧菌的主要致病物质是( )A、鞭毛B、菌毛C、荚膜D、外毒素E、内毒素39、霍乱弧菌常用的培养基是( )A、巧克力培养基B、SS培养基C、碱性蛋白胨水D、庖肉培养基E、血琼脂平板40、关于霍乱弧菌生物学性状,不正确的是( )A、霍乱弧菌的抵抗力较弱B、霍乱弧菌耐碱不耐酸C、在霍乱弧菌感染病人的粪便悬滴标本中,可见“鱼群状穿梭”D、El Tor生物型霍乱弧菌抵抗力强,是因为其有芽胞E、霍乱弧菌有单端鞭毛,所以运动活泼41、关于霍乱肠毒素,不正确的是( )A、是霍乱弧菌的主要致病物质B、由一个A亚单位和5个B亚单位组成C、B亚单位是结合亚单位D、A亚单位是毒性亚单位E、与受体结合,可使细胞内腺甘环化酶活性下降42、关于对霍乱的叙述,不正确的是( )A、属于烈性传染病B、经口传播C、病愈后,有些病人可长期带菌D、病后可获得短暂的免疫力E、对霍乱的免疫力主要是SIgA的作用43、均属于专性厌氧菌的是( )A、破伤风梭菌、肉毒梭菌、结核分枝杆菌B、产气荚膜梭菌、大肠埃希菌、肉毒梭菌C、肉毒梭菌、破伤风梭菌、脆弱类杆菌D、破伤风梭菌、变形杆菌、消化链球菌E、肉毒梭菌、破伤风梭菌、淋病奈瑟菌44、下列细菌中属于专性厌氧菌的是( )A、脑膜炎奈瑟菌B、消化链球菌C、肺炎链球菌D、葡萄球菌E、大肠埃希菌45、以气溶胶吸入方式引起机体抵抗力低下人群肺炎的细菌是()A.肺炎链球菌B.脑膜炎球菌C.军团菌D.绿脓杆菌E.流感杆菌46、在人体肠道正常菌群中,数量占绝对优势的细菌是( )A、大肠埃希菌B、无芽胞厌氧菌C、沙门菌D、变形杆菌E、志贺菌47、关于对厌氧芽胞杆菌的叙述,错误的是( )A、属于梭状芽胞杆菌属B、均为革兰阳性杆菌C、均通过伤口感染D、可引起特有的临床症状E、广泛分布于自然界的土壤中48、关于破伤风梭菌的叙述,错误的是( )A、为革兰阳性杆菌B、具有周鞭毛C、芽胞圆形,直径大于菌体宽度,位于菌体顶端D、芽胞抵抗力强E、通过伤口感染,细菌侵入血流而致病49、引起破伤风梭菌感染最常见的创伤是( )A、因搔痒抓破的伤口B、被宠物抓破的伤口C、战伤或深度刺伤D、有厌氧菌感染的伤口E、大面积的烧伤50、破伤风的紧急预防应注射( )A、类毒素B、抗生素C、抗毒素D、干扰素E、丙种球蛋白51、不小心被土壤中的锈铁钉深刺造成外伤时,首先应考虑给予注射( )A、破伤风减毒活疫苗B、丙种球蛋白C、白百破三联疫苗D、破伤风类毒素E、破伤风抗毒素52、破伤风抗毒素治疗破伤风的机制是( )A、中和游离的外毒素B、中和与神经细胞结合的外毒素C、抑制破伤风梭菌的生长D、在补体参与下溶解破伤风梭菌E、抑制破伤风梭菌产生外毒素53、下列细菌中不引起败血症的细菌是( )A、金黄色葡萄球菌B、大肠埃希菌C、肉毒梭菌D、肺炎链球菌E、脑膜炎奈瑟菌54、可疑肉毒毒素中毒的患者,微生物学检查采集的标本应是( )A、患者的粪便B、伤口的渗出液C、患者的脑脊液D、患者吃剩的食物E、患者的血液55、可阻碍乙酰胆碱的释放,导致肌肉弛缓型麻痹的是( )A、破伤风痉挛毒素B、肉毒毒素C、脑膜炎奈瑟菌的内毒素D、乙型溶血性链球菌溶素OE、霍乱肠毒素56、与结核杆菌胞内寄生性有关的物质是()A.磷脂B.索状因子C.硫酸脑苷酯D.蜡质D E.内毒素57、结核杆菌的特点中不包括()A.抗酸染色阳性B.专性需氧,营养要求高C.生长缓慢D.对外界抵抗力低,不易产生耐药性E.细胞壁脂质是其致病主要物质二、名词解释1、抗O试验2、肥大(Widal)试验3、OT试验三、填空题1、金黄色葡萄球菌产生的酶使化脓性感染表现为局限性特征,而链球菌产生的酶使感染易于扩散。



微生物学检验选择复习题与参考答案一、单选题(共90题,每题1分,共90分)1、G+菌细胞壁最主要的组成成分是A、磷壁酸B、脂蛋白C、肽聚糖D、磷脂E、脂多糖正确答案:C2、关于脂多糖的叙述哪项是不正确的(C)(难)A、可称为细菌内毒素B、存在于革兰阴性菌的外膜C、具有多种生物学活性D、由磷脂和脂蛋白组成E、由脂类和多糖组成正确答案:D3、用于培养肠道致病菌的强选择性培养基是( )A、SS平板B、巧克力平板C、乳糖发酵管D、中国蓝平板E、双糖铁培养基正确答案:A4、下列革兰阳性菌为细胞内寄生菌的是( )(中)A、产单核细胞李斯特菌B、GVC、炭疽芽胞菌D、白喉棒状杆菌E、红斑丹毒丝菌正确答案:A5、对革兰阴性杆菌,出现下列哪种特征,可怀疑为非发酵菌( C )A、发酵葡萄糖B、动力阴性C、氧化利用麦芽糖D、触酶阳性E、氧化酶阳性正确答案:E6、KIA 培养基分为两层,其上、下层所含物质是(E)(中)A、上层是固体培养基,含有葡萄糖,下层是半固体培养基,含有乳糖B、上层是固体培养基,含有乳糖,下层是半固体培养基,含有葡萄糖C、上层是半固体培养基,含有葡萄糖,下层是固体培养基,含有乳糖D、两层均含有葡萄糖和乳糖E、上层是半固体培养基,含有乳糖,下层是固体培养基,含有葡萄糖正确答案:D7、有关新型隐球菌的感染方式,下列说法正确的就是:( )A、鸽子粪便-土壤-经呼吸道传播B、尘埃-呼吸道传播C、咳痰,飞沫传播D、皮肤破烂,接触传播E、粪便-土壤-经消化道传播正确答案:A8、关于铜绿假单胞菌的生化反应,错误的是( )A、氧化酶阳性B、精氨酸双水解酶阳性C、乙酰胺酶阳性D、硝酸盐还原试验阴性E、在OF培养基上能氧化利用葡萄糖、产酸正确答案:D9、破伤风的特异性治疗,可用( )A、细菌素B、溶血素C、破伤风菌苗D、抗毒素E、类毒素正确答案:D10、下列属于鉴别培养基的是(B)(易)A、肉汤培养基.B、EMB培养基C、血琼脂培养基D、巧克力琼脂培养基E、庖肉培养基正确答案:B11、可用于鉴别细菌的细胞质内的颗粒A、异染颗粒B、糖原C、核质D、核糖体E、脂肪颗粒正确答案:A12、测量细菌大小的单位是A、毫米(mm)B、纳克(ng)C、微米(μm)D、道尔顿(Dalton)E、纳米(nm)正确答案:C13、下列哪种物质是原核细胞型微生物所特有的化学成分(C)(中)A、蛋白质B、脂质C、几丁质D、无机盐E、肽聚糖正确答案:E14、关于葡萄球菌生物学性状,叙述不正确的是( )A、营养要求不高B、在高盐甘露醇平板上生长受抑制C、触酶阳性D、在生长过程中可有色素产生E、某些菌种在血平板上形成透明溶血环正确答案:B15、葡萄球菌感染可引起烫伤样皮肤综合征的是( )A、表皮剥脱毒素B、杀白细胞素C、溶血素D、肠毒素E、毒素休克综合征毒素正确答案:A16、大多数细菌的最适环境pH为A、3.2~3.6B、4.2~4.6C、5.2~5.6D、6.2~6.6E、7.2~7.6正确答案:E17、关于细菌产生的色素,错误的是( )A、分两类:脂溶性和水溶性B、色素产生需一定的条件C、可进行光合作用D、有助于鉴别细菌E、其功能尚不清楚正确答案:C18、属革兰阴性专性厌氧杆菌的细菌是( )A、破伤风杆菌B、类杆菌C、白喉杆菌D、双歧杆菌E、肉毒杆菌正确答案:B19、肠杆菌科细菌不具有的是( )A、鞭毛B、菌毛C、荚膜D、质粒E、芽胞正确答案:E20、测定细菌DNA中G+C含量摩尔百分比可作为()。
10护理学本科医学微生物学阶段练习2班级姓名学号呼吸道传播细菌一、单选题1.下列细菌中繁殖最慢的是()A.大肠埃希菌 B.葡萄球菌 C.脑膜炎奈瑟菌D.结核分枝杆菌 E.肺炎链球菌2.与结核分枝杆菌抗酸性有关的成分是()A.索状因子 B.磷脂 C.分枝菌酸 D.蜡脂 E.硫酸脑苷脂3.卡介苗属于下列哪种变异()A.毒力变异 B.酶活性变异 C.结构变异 D.抗原性变异 E.耐药性变异4.不以内毒素或外毒素为致病物质的细菌是()A.白喉棒状杆菌 B.炭疽芽胞杆菌 C.结核分枝杆菌 D.葡萄球菌 E.链球菌5.人体对结核分枝杆菌的免疫特点是()A.以体液和细胞免疫 B.以体液免疫为主 C.为有菌免疫D.不能通过人工主动免疫获得 E.可引起Ⅰ超敏反应6.从痰涂片检出细菌,具有临床诊断意义的是()A.表皮葡萄球菌B. 金黄色葡萄球菌 C.甲型溶血性链球菌D.脑膜炎奈瑟菌E.结核分枝杆菌7.痰结核杆菌培养,应选用的培养基是()A.血琼脂平板 B.巧克力色培养基 C.罗氏培养基D.沙包培养基 E.普通琼脂培养基8.卡介苗是()A.经甲醛处理后的人型结核杆菌 B.加热处理后的人型结核杆菌C.发生了抗原变异的牛型结核杆菌 D.保持免疫原性,减毒的活的牛型结核杆菌E.保持免疫原性,减毒活的人型结核杆菌9.卡介苗的接种对象主要是()A.严重结核病人,结核菌素试验阴性患者 B.结核菌素试验阳性者C.OT试验阴性的麻疹患儿 D.新生儿和结核菌素试验阴性的儿童 E.C+D 10.关于结核菌素试验,下列哪项是错误的()A.可用于选择卡介苗接种对象 B.检测机体细胞免疫和体液免疫状况C.作为婴幼儿结核病的辅助诊断D.皮肤反应程度以局部红肿、硬结的直径为标准E.属于皮肤迟发型超敏反应11.不符合脑膜炎奈瑟菌送检标本要求的是()A.采集标本注意无菌操作 B.根据该病原菌主要存在部位C.采集标本一般应在使用抗菌药物之前 D.采集的标本要立即送检E.标本送检过程中要立即保持低温和干燥12.脑膜炎奈瑟菌的主要致病物质是()A.外毒素 B.内毒素 C.微荚膜 D.菌毛 E.溶血毒素13.自鼻咽拭子中分离出一株细菌,其菌落周围有草绿色溶血环,胆汁溶解试验阳性,最可能是哪种细菌()A.乙性溶血型链球菌 B.甲型溶血型链球菌 C、绿脓杆菌D.副溶血性弧菌 E.肺炎链球菌14.肺炎链球菌的致病因素主要是()A.内毒素 B.外毒素 C.荚膜 D.菌毛 E.侵袭性酶15.能在无生命培养基上生长繁殖的最小的原核细胞型微生物是()A. 细菌B. 衣原体C. 支原体 C. 立克次体 E. 病毒16.关于支原体的生物学性状,下述错误的是()A.无细胞壁B.能通过滤菌器C.呈多形性D.有独特生活周期E.胞膜胆固醇含量高17.支原体与病毒的相同点是()A.能在无生命培养基上生长繁殖B.个体微小,能通过滤菌器C.胞膜中含大量胆固醇D.对抗生素敏感E.有两种核酸18.下列哪项不是白喉棒状杆菌感染的特点()A.主要经呼吸道感染 B.白喉的早期致死原因是假膜脱落引起的窒息C.有异染颗粒 D.白喉棒状杆菌在局部繁殖后入血E.只有携带β-棒状杆菌噬菌体的溶原性白喉杆菌才能产生白喉毒素19.百日咳杆菌的分离培养应采用()A.鲍金(BG)培养基 B.巧克力培养基 C. 伊红-亚甲蓝培养基D.罗氏培养基 E.亚蹄酸钾培养基20.百日咳杆菌属于()A.假单胞菌属 B.奈瑟菌属 C。
第7章肠道杆菌(Enteric bacilli)
第一节概述
肠道杆菌是指寄生在人和动物肠道中的大群革兰氏阴性杆菌, 它们为兼性厌氧菌, 属于肠杆菌科。
本科细菌不产生芽孢, 形态相似,• 但含有多种酶类, 故生化反应繁多, 根据它们的特殊构造、生化特性和抗原结构等方面的特点, 可将肠杆菌科的细菌分为6族13属。
志贺氏菌属、沙门氏菌属及部分埃希氏菌属是人类的重要致病菌。
其它各属细菌大多是肠内常居菌或机会致病菌。
一、生物学性状
(一)形态肠杆菌科的细菌皆为革兰氏阴性的短小杆菌, 多数有周鞭毛, 有些菌株有性菌毛可传递质粒。
(二)生化特性生化反应活泼, 能分解多种糖类和蛋白质, 形成不同的代谢产物, 这都可作为鉴别细菌的依据。
一般说来非致病性的埃希氏菌属和肠杆菌属细菌具有β-半乳糖甘酶,而致病性的志贺氏菌属和沙门氏菌属细菌无此酶, 可利用乳糖发酵试验作为鉴别肠道致病菌与非致病菌的重要依据。
(三)抗原构造与血清学分型
1.抗原构造复杂: 有菌体(O)抗原、鞭毛(H)抗原和表面(K)抗原三和种。
(1)O抗原: 脂多糖分子最外层, 由重复的低聚糖所组成的聚合体
(2)H抗原: 是组成细菌鞭毛的蛋白质成分, •按多肽链的氨基酸排列顺序及空间构型决定鞭毛抗原的特异性。
(3)K抗原: 是多糖质, 它存在于荚膜或微荚膜中。
2.血清学分型是用血清学方法检查待测菌株细菌表面的特异性群或型抗原, 这需要单因子血清做凝集试验。
(四)抵抗力
肠杆菌科的细菌无芽孢, 对热力和一般消毒剂的抵抗力都不强。
雾化器,是医院感染中重要的传染来源。
二、微生物学诊断原则
粪便是最常采取的标本, 初次分离时, 一般采用具有选择和鉴别性质的培养基, 如S.S.琼脂和中国兰培基。
对肠科细菌的鉴定, 主要是根据生化反应。
第二节埃希氏菌属(Escherichia)
大肠埃希氏菌可分为致病性和非致病性两大类,非致病菌是人和哺乳动物肠道中的正常菌群,且可帮助机体合成维生素B、K和大肠菌素(colicins)等, •甚至在一定程度上还能阻止外来的病原体生长、繁殖及引起疾病。
生物间若失去平衡或因机体过度虚弱或外伤而其它无菌部位时,它们也会乘机侵害, •成为机会致病菌。
一、致病性
(一)致病物质:
1.定居因子(或称粘附素):为大肠杆菌一种特殊菌毛,抗原性强,可粘附于宿主体肠壁。
2.肠毒素分耐热不耐热两种。
a 不耐热肠毒素(heat labile enterotoxin,LT)60C时30分钟灭活。
与霍乱弧菌外
毒素有80%同源性。
分A、B亚单位,A为毒性部分,B为结合部位,可与肠粘膜上皮细胞膜表面GM1神经节苷脂结合,使ATP转化为cAMP。
b 耐热肠毒素(heat stable enterotoxin,ST)100 C 20分钟仍有活性。
分a、b两个
活性部分,其中以后者为主。
作用是使cGMP升高。
(二) 所致疾病:
1.腹泻
1.产肠毒素性大肠杆菌(enterotoxigentic E. coli 简称ETEC): •主要引起儿童和旅游者腹。
产生两种肠毒素即不耐热毒素(简称LT)和耐热毒素(ST)。
LT分子量大, 其致病机制与霍乱弧菌肠毒素的作用相似, ST的分子量小。
•ST引起腹泻的机制, 是活化了细胞上的鸟苷酸球化酶ETEC的致病, 与它具有菌毛亦有关。
2.肠致病性大肠杆菌(EPEC): 主要引起婴儿腹泻, 严重者可致死。
成人多为带菌者。
3.肠侵袭性大肠杆菌(EIEC)引起较大的儿童和成人腹泻。
引起类似痢疾症状的炎症、溃疡和腹泻。
4.肠出血性大肠杆菌(EHEC):产志贺毒素样细胞毒素,主要引起血性便。
主要菌型是O157:H7
特点ETEC EPEC EIEC EHEC 致病机理LT、ST侵袭肠粘膜细胞产志贺样毒素腹泻类型水泻水泻菌痢样血性便
易感人群婴儿和成人婴儿成人和儿童成人儿童(二)肠外感染(化脓性炎症)
大肠埃希氏菌可由外部侵入, 但更多的是内源性感染。
主要引起尿道感染和腹腔脏器感染。
人体的局部或全身抵抗力降低是自身感染的重要条件。
二、免疫性
主要靠机体的非特异性防御功能, 包括维持肠道中正常菌群的平衡。
三、卫生细菌学检验的指示菌
1. 大肠菌值是指能检出大肠菌的最小样品量(ml)。
大肠菌指数是指1000ml样品中检出的大肠菌群数, 卫生部规定的饮水卫生标准是大肠菌值>333, 大肠菌指数<3。
2. 细菌总数测定即检测每毫升或每克样品中所含细菌总数。
第三节沙门氏菌属(Salmonella)
是人和动物的常见病原菌, 可以引起人类多种疾病如胃肠炎、•肠热症、局灶性感染等。
一、生物学性状
(一)形态染色: 革兰氏阴性杆菌,无芽孢,均有周鞭毛,能运动,可与痢疾杆菌属区别。
(二)培养及生化特性: 普通培养基上胆盐培养基上, 接种在SS•鉴别培养基上均生长良好。
(三)抗原构造与分组分型
1. 菌体(O)抗原: 能耐煮沸2小时以上, 不被乙醇、衡酸及0.1%苯酚破坏。
将沙门氏菌与相应的抗菌体抗原的免疫血清混合时,• 可出现颗粒状凝集。
2. 鞭毛(H)抗原: 不耐热, 乙醇、稀酸处理易失去其抗原性。
3. 表面抗原: 或称K抗原, ①Vi抗原(毒力抗原):是包在菌体O•抗原外层的一种微荚膜成分;
②M抗原(粘液抗原):可阻止O•抗原与相应抗体不发生凝集反应; ③S抗原: 是一种表面抗原, 可被盐酸破坏, 故与O抗原不同。